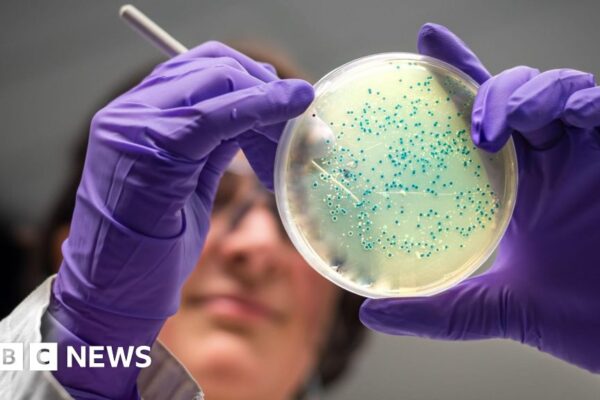

Sudden, heavy rain in Indian Kashmir leaves dozens dead, more than 200 missing
Facebook Tweet Email Link A sudden burst of heavy rain has claimed dozens of lives in India-administered Kashmir and sparked frantic rescue efforts, the second recent disaster to underscore the vulnerability of those living in the Himalayas to the effects of extreme weather. At least 46 people have died and more than 200 are missing…